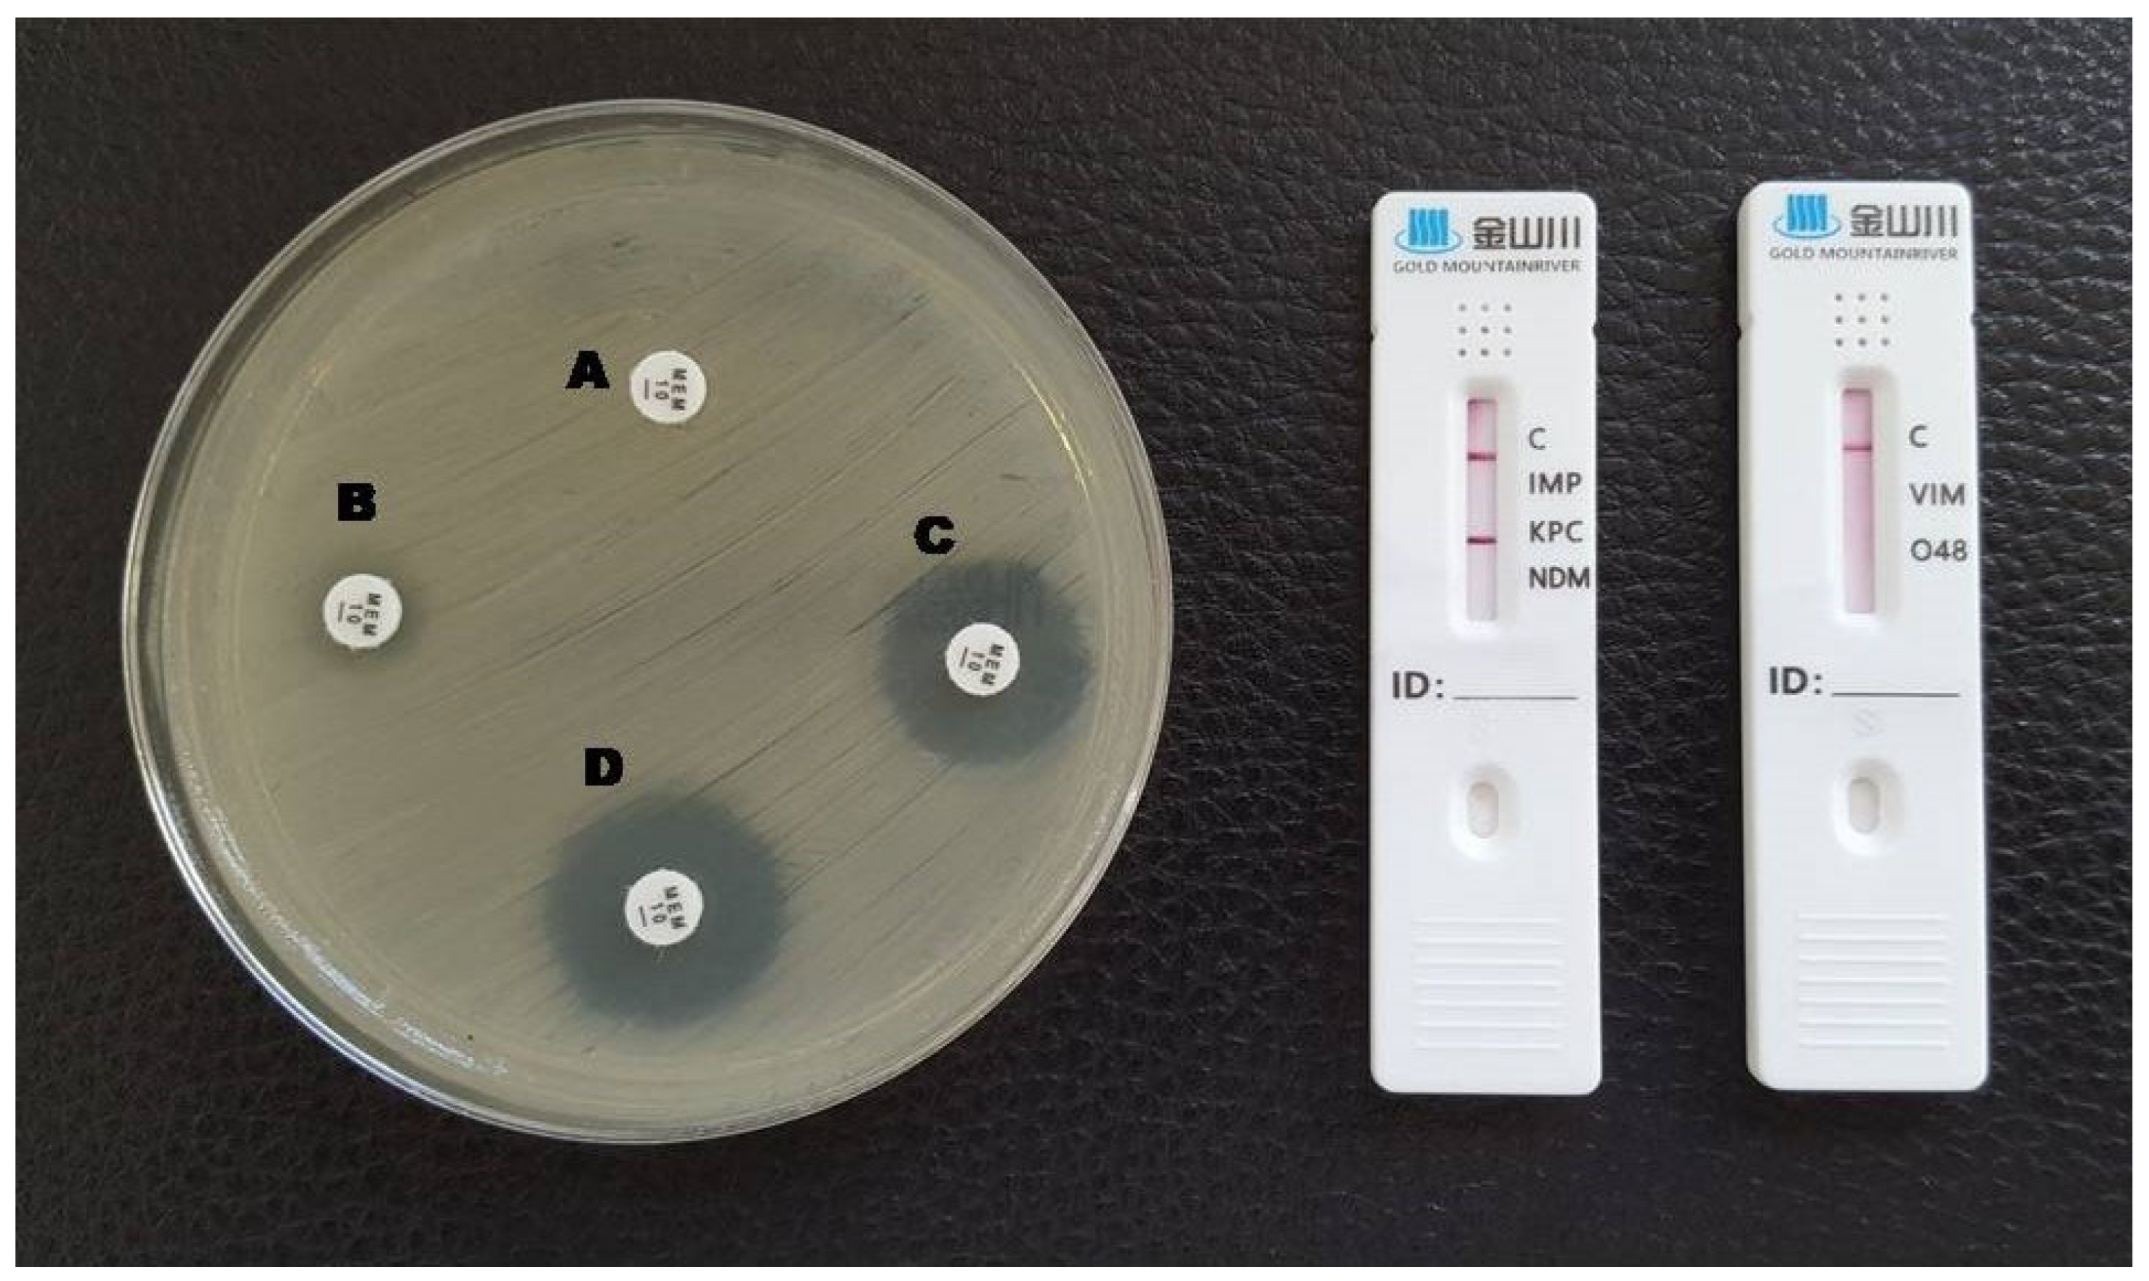
Antibiotics 12 00771 g001 Antibiotics 12 00771 g001
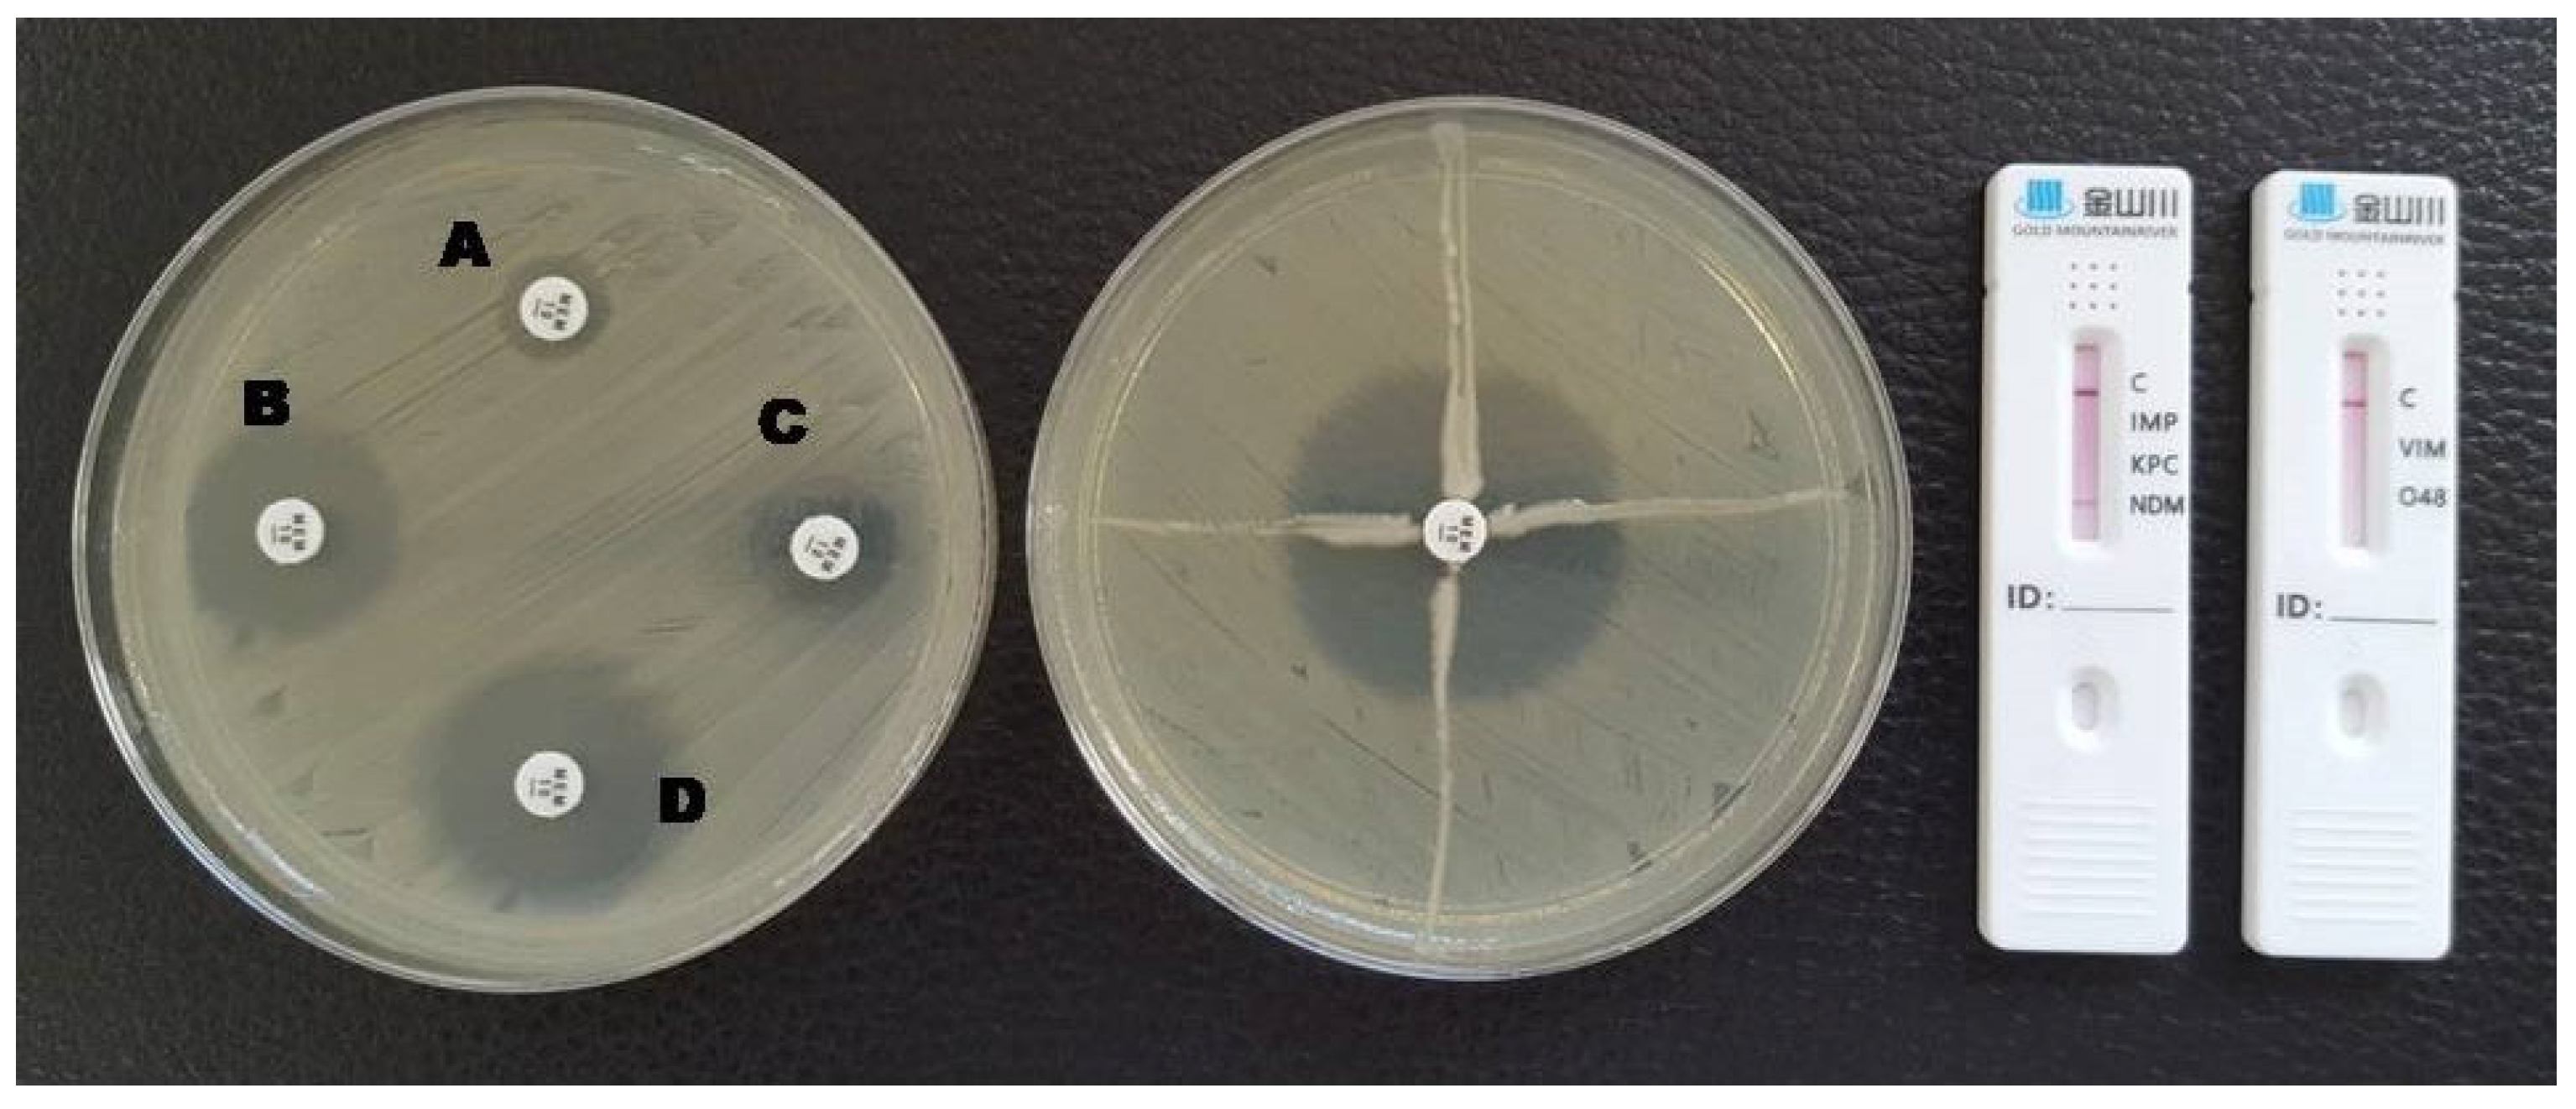
Antibiotics 12 00771 g003 Antibiotics 12 00771 g003
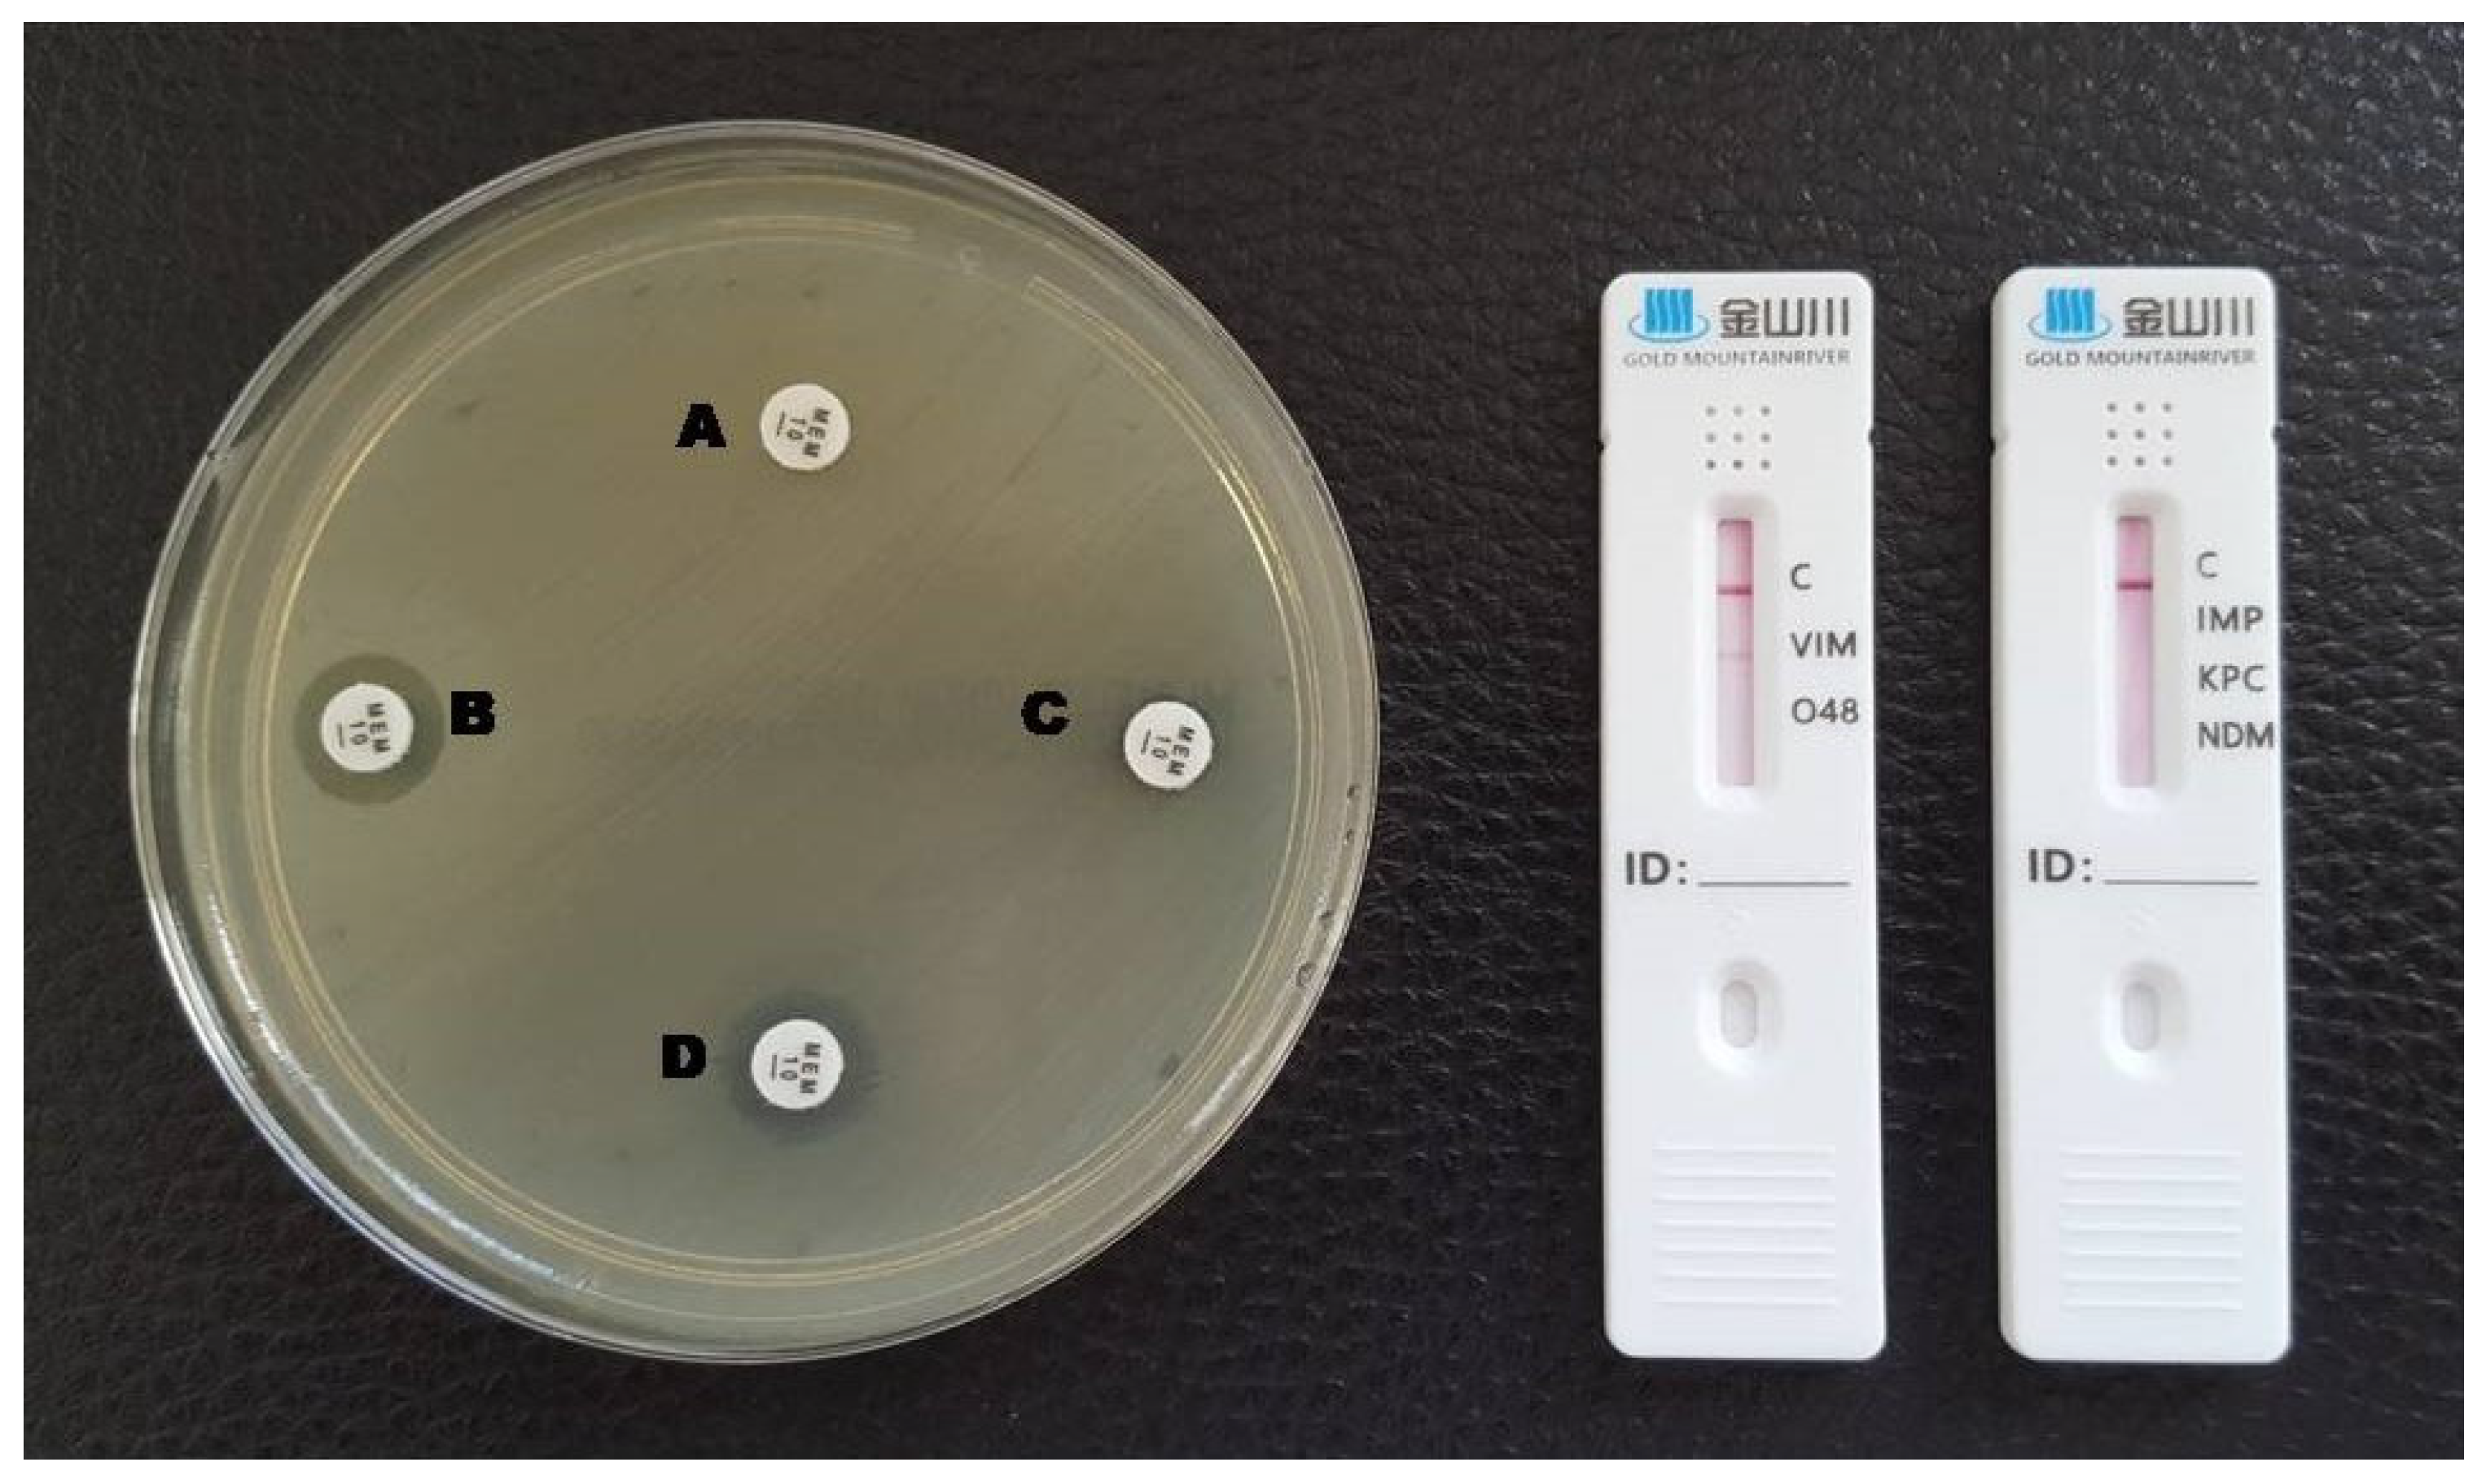
Antibiotics 12 00771 g005 Antibiotics 12 00771 g005

Replacement of the Double Meropenem Disc Test with a Lateral Flow Assay for the Detection of Carbapenemase-Producing Enterobacterales and Pseudomonas aeruginosa in Clinical Laboratory Practice
Abstract
1. Introduction
2. Results
3. Discussion
4. Materials and Methods
4.1. Study Design
4.2. Double Meropenem Disc Test
4.3. Modified Hodge Test
4.4. Detection of blaNDM by PCR
4.5. Carbapenem-Resistant K.N.I.V.O. Detection K-Set
4.6. Statistical Analysis
5. Conclusions
Supplementary Materials
Author Contributions
Funding
Institutional Review Board Statement
Informed Consent Statement
Data Availability Statement
Acknowledgments
Conflicts of Interest
References
- Alfei, S.; Schito, A.M. β-lactam antibiotics and β-lactamase enzymes inhibitors, part 2: Our limited resources. Pharmaceuticals 2022, 15, 476. [Google Scholar] [CrossRef] [PubMed]
- Meletis, G. Carbapenem resistance: Overview of the problem and future perspectives. Ther. Adv. Infect. Dis. 2016, 3, 15–21. [Google Scholar] [CrossRef]
- Tzouvelekis, L.S.; Markogiannakis, A.; Psichogiou, M.; Tassios, P.T.; Daikos, G.L. Carbapenemases in Klebsiella pneumoniae and other Enterobacteriaceae: An evolving crisis of global dimensions. Clin. Microbiol. Rev. 2012, 25, 682–707. [Google Scholar] [CrossRef] [PubMed]
- Meletis, G.; Exindari, M.; Vavatsi, N.; Sofianou, D.; Diza, E. Mechanisms responsible for the emergence of carbapenem resistance in Pseudomonas aeruginosa. Hippokratia 2012, 16, 303–307. [Google Scholar] [PubMed]
- Partridge, S.R.; Kwong, S.M.; Firth, N.; Jensen, S.O. Mobile genetic elements associated with antimicrobial resistance. Clin. Microbiol. Rev. 2018, 31, e00088-17. [Google Scholar] [CrossRef] [PubMed]
- Castanheira, M.; Simner, P.J.; Bradford, P.A. Extended-spectrum β-lactamases: An update on their characteristics, epidemiology and detection. JAC Antimicrob. Resist. 2021, 3, dlab092. [Google Scholar] [CrossRef] [PubMed]
- Ambler, R.P. The structure of beta-lactamases. Philos. Trans. R. Soc. Lond. B Biol. Sci. 1980, 289, 321–331. [Google Scholar]
- Queenan, A.M.; Bush, K. Carbapenemases: The versatile beta-lactamases. Clin. Microbiol. Rev. 2007, 20, 440–458. [Google Scholar] [CrossRef]
- Poirel, L.; Pitout, J.D.; Nordmann, P. Carbapenemases: Molecular diversity and clinical consequences. Future Microbiol. 2007, 2, 501–512. [Google Scholar] [CrossRef]
- Nordmann, P.; Cuzon, G.; Naas, T. The real threat of Klebsiella pneumoniae carbapenemase-producing bacteria. Lancet Infect. Dis. 2009, 9, 228–236. [Google Scholar] [CrossRef]
- Rapp, R.P.; Urban, C. Klebsiella pneumoniae carbapenemases in Enterobacteriaceae: History, evolution, and microbiology concerns. Pharmacotherapy 2012, 32, 399–407. [Google Scholar] [CrossRef] [PubMed]
- Walther-Rasmussen, J.; Høiby, N. OXA-type carbapenemases. J. Antimicrob. Chemother. 2006, 57, 373–383. [Google Scholar] [CrossRef] [PubMed]
- Walsh, T.R.; Toleman, M.A.; Poirel, L.; Nordmann, P. Metallo-beta-lactamases: The quiet before the storm? Clin. Microbiol. Rev. 2005, 18, 306–325. [Google Scholar] [CrossRef] [PubMed]
- Zhao, W.H.; Hu, Z.Q. IMP-type metallo-β-lactamases in Gram-negative bacilli: Distribution, phylogeny, and association with integrons. Crit. Rev. Microbiol. 2011, 37, 214–226. [Google Scholar] [CrossRef] [PubMed]
- Zhao, W.H.; Hu, Z.Q. Epidemiology and genetics of VIM-type metallo-β-lactamases in Gram-negative bacilli. Future Microbiol. 2011, 6, 317–333. [Google Scholar] [CrossRef] [PubMed]
- Nordmann, P.; Poirel, L.; Walsh, T.R.; Livermore, D.M. The emerging NDM carbapenemases. Trends Microbiol. 2011, 19, 588–595. [Google Scholar] [CrossRef] [PubMed]
- Quale, J.; Bratu, S.; Gupta, J.; Landman, D. Interplay of efflux system, ampC, and oprD expression in carbapenem resistance of Pseudomonas aeruginosa clinical isolates. Antimicrob. Agents Chemother. 2006, 50, 1633–1641. [Google Scholar] [CrossRef] [PubMed]
- Poirel, L.; Potron, A.; Nordmann, P. OXA-48-like carbapenemases: The phantom menace. J. Antimicrob. Chemother. 2012, 67, 1597–1606. [Google Scholar] [CrossRef] [PubMed]
- Girlich, D.; Poirel, L.; Nordmann, P. Value of the modified Hodge test for detection of emerging carbapenemases in Enterobacteriaceae. J. Clin. Microbiol. 2012, 50, 477–479. [Google Scholar] [CrossRef] [PubMed]
- Tamma, P.D.; Simner, P.J. Phenotypic detection of carbapenemase-producing organisms from clinical isolates. J. Clin. Microbiol. 2018, 56, e01140-18. [Google Scholar] [CrossRef]
- Boutal, H.; Moguet, C.; Pommiès, L.; Simon, S.; Naas, T.; Volland, H. The revolution of lateral flow assay in the field of AMR detection. Diagnostics 2022, 12, 1744. [Google Scholar] [CrossRef] [PubMed]
- Bernabeu, S.; Bonnin, R.A.; Dortet, L. Comment on: Comparison of three lateral flow immunochromatographic assays for the rapid detection of KPC, NDM, IMP, VIM and OXA-48 carbapenemases in Enterobacterales. J. Antimicrob. Chemother. 2023, 78, 314–317. [Google Scholar] [CrossRef] [PubMed]
- Hemwaranon, P.; Srisrattakarn, A.; Lulitanond, A.; Tippayawat, P.; Tavichakorntrakool, R.; Wonglakorn, L.; Daduang, J.; Chanawong, A. Recombinase Polymerase Amplification Combined with Lateral Flow Strip for Rapid Detection of OXA-48-like Carbapenemase Genes in Enterobacterales. Antibiotics 2022, 11, 1499. [Google Scholar] [CrossRef]
- Vasilakopoulou, A.; Karakosta, P.; Vourli, S.; Kalogeropoulou, E.; Pournaras, S. Detection of KPC, NDM and VIM-Producing Organisms Directly from Rectal Swabs by a Multiplex Lateral Flow Immunoassay. Microorganisms 2021, 9, 942. [Google Scholar] [CrossRef]
- Mendez-Sotelo, B.J.; López-Jácome, L.E.; Colín-Castro, C.A.; Hernández-Durán, M.; Martínez-Zavaleta, M.G.; RiveraBuendía, F.; Velázquez-Acosta, C.; Rodríguez-Zulueta, A.P.; MorfínOtero, M.d.R.; Franco-Cendejas, R. Comparison of Lateral Flow Immunochromatography and Phenotypic Assays to PCR for the Detection of CarbapenemaseProducing Gram-Negative Bacteria, a Multicenter Experience in Mexico. Antibiotics 2023, 12, 96. [Google Scholar] [CrossRef]
- Meletis, G.; Vavatsi, N.; Exindari, M.; Protonotariou, E.; Sianou, E.; Haitoglou, C.; Sofianou, D.; Pournaras, S.; Diza, E. Accumulation of carbapenem resistance mechanisms in VIM-2-producing Pseudomonas aeruginosa under selective pressure. Eur. J. Clin. Microbiol. Infect. Dis. 2014, 33, 253–258. [Google Scholar] [CrossRef]
- Josa, M.D.; Leal, R.; Rojas, J.; Torres, M.I.; Cortés-Muñoz, F.; Esparza, G.; Reyes, L.F. Comparative evaluation of phenotypic synergy tests versus RESIST-4 O.K.N.V. and NG Test Carba 5 lateral flow immunoassays for the detection and differentiation of carbapenemases in Enterobacterales and Pseudomonas aeruginosa. Microbiol. Spectr. 2022, 10, e01080-21. [Google Scholar] [CrossRef]
- Sadek, M.; Bouvier, M.; Kerbol, A.; Poirel, L.; Nordmann, P. Evaluation of novel immunological rapid test (K.N.I.V.O. Detection K-Set) for rapid detection of carbapenemase producers in multidrug-resistant gram negatives. Diagn. Microbiol. Infect. Dis. 2022, 104, 115761. [Google Scholar] [CrossRef] [PubMed]
- Lawandi, A.; Yek, C.; Kadri, S.S. IDSA guidance and ESCMID guidelines: Complementary approaches toward a care standard for MDR Gram-negative infections. Clin. Microbiol. Infect. 2022, 28, 465–469. [Google Scholar] [CrossRef]
- Tamma, P.D.; Goodman, K.E.; Harris, A.D.; Tekle, T.; Roberts, A.; Taiwo, A.; Simner, P.J. Comparing the outcomes of patients with carbapenemase-producing and non-carbapenemase-producing carbapenem-resistant Enterobacteriaceae bacteremia. Clin. Infect. Dis. 2017, 64, 257–264. [Google Scholar] [CrossRef] [PubMed]
- Tsakris, A.; Poulou, A.; Pournaras, S.; Voulgari, E.; Vrioni, G.; Themeli-Digalaki, K.; Petropoulou, D.; Sofianou, D. A simple phenotypic method for the differentiation of metallo-b-lactamases and class A KPC carbapenemases in Enterobacteriaceae clinical isolates. J. Antibicrob. Chemother. 2010, 65, 1664–1671. [Google Scholar] [CrossRef] [PubMed]
- Protonotariou, E.; Meletis, G.; Pilalas, D.; Mantzana, P.; Tychala, A.; Kotzamanidis, C.; Papadopoulou, D.; Papadopoulos, T.; Polemis, M.; Metallidis, S.; et al. Polyclonal endemicity of carbapenemase-producing Klebsiella pneumoniae in ICUs of a Greek tertiary care hospital. Antibiotics 2022, 11, 149. [Google Scholar] [CrossRef] [PubMed]
- Pasteran, F.; Veliz, O.; Rapoport, M.; Guerriero, L.; Corso, A. Sensitive and specific modified Hodge test for KPC and metallo-beta-lactamase detection in Pseudomonas aeruginosa by use of a novel indicator strain, Klebsiella pneumoniae ATCC 700603. J. Clin. Microbiol. 2011, 49, 4301–4303. [Google Scholar] [CrossRef]
- Karampatakis, T.; Antachopoulos, C.; Tsakris, A.; Roilides, E. Molecular epidemiology of carbapenem-resistant Pseudomonas aeruginosa in an endemic area: Comparison with global data. Eur. J. Clin. Microbiol. Infect. Dis. 2018, 37, 1211–1220. [Google Scholar] [CrossRef]
- Protonotariou, E.; Poulou, A.; Politi, L.; Meletis, G.; Chatzopoulou, F.; Malousi, A.; Metallidis, S.; Tsakris, A.; Skoura, L. Clonal outbreak caused by VIM-4-producing Proteus mirabilis in a Greek tertiary-care hospital. Int. J. Antimicrob. Agents 2020, 56, 106060. [Google Scholar] [CrossRef] [PubMed]
- Clinical and Laboratory Standards Institute. Performance Standards for Antimicrobial Susceptibility Testing: 19th Informational Supplement; CLSI document M100–SClinical and Laboratory Standards Institute: Wayne, PA, USA, 2011. [Google Scholar]
- Nordmann, P.; Poirel, L.; Carrër, A.; Toleman, M.A.; Walsh, T.R. How to detect NDM-1 producers. J. Clin. Microbiol. 2011, 49, 718–721. [Google Scholar] [CrossRef]

Disclaimer/Publisher’s Note: The statements, opinions and data contained in all publications are solely those of the individual author(s) and contributor(s) and not of MDPI and/or the editor(s). MDPI and/or the editor(s) disclaim responsibility for any injury to people or property resulting from any ideas, methods, instructions or products referred to in the content. |
© 2023 by the authors. Licensee MDPI, Basel, Switzerland. This article is an open access article distributed under the terms and conditions of the Creative Commons Attribution (CC BY) license (https://creativecommons.org/licenses/by/4.0/).
Share and Cite
Tychala, A.; Meletis, G.; Mantzana, P.; Kassomenaki, A.; Katsanou, C.; Daviti, A.; Kouroudi, L.; Skoura, L.; Protonotariou, E. Replacement of the Double Meropenem Disc Test with a Lateral Flow Assay for the Detection of Carbapenemase-Producing Enterobacterales and Pseudomonas aeruginosa in Clinical Laboratory Practice. Antibiotics 2023, 12, 771. https://doi.org/10.3390/antibiotics12040771
Tychala A, Meletis G, Mantzana P, Kassomenaki A, Katsanou C, Daviti A, Kouroudi L, Skoura L, Protonotariou E. Replacement of the Double Meropenem Disc Test with a Lateral Flow Assay for the Detection of Carbapenemase-Producing Enterobacterales and Pseudomonas aeruginosa in Clinical Laboratory Practice. Antibiotics. 2023; 12(4):771. https://doi.org/10.3390/antibiotics12040771
Chicago/Turabian StyleTychala, Areti, Georgios Meletis, Paraskevi Mantzana, Angeliki Kassomenaki, Charikleia Katsanou, Aikaterini Daviti, Lydia Kouroudi, Lemonia Skoura, and Efthymia Protonotariou. 2023. "Replacement of the Double Meropenem Disc Test with a Lateral Flow Assay for the Detection of Carbapenemase-Producing Enterobacterales and Pseudomonas aeruginosa in Clinical Laboratory Practice" Antibiotics 12, no. 4: 771. https://doi.org/10.3390/antibiotics12040771
APA StyleTychala, A., Meletis, G., Mantzana, P., Kassomenaki, A., Katsanou, C., Daviti, A., Kouroudi, L., Skoura, L., & Protonotariou, E. (2023). Replacement of the Double Meropenem Disc Test with a Lateral Flow Assay for the Detection of Carbapenemase-Producing Enterobacterales and Pseudomonas aeruginosa in Clinical Laboratory Practice. Antibiotics, 12(4), 771. https://doi.org/10.3390/antibiotics12040771

